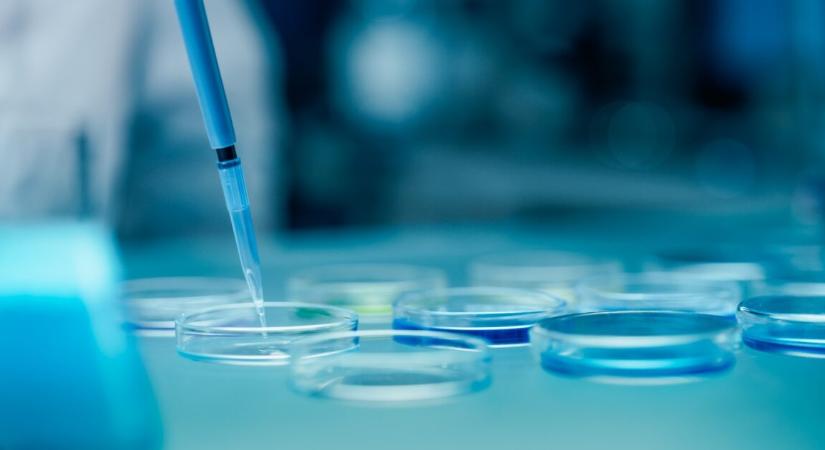
Nincs több remény – közel 10 év után azonosították a 22 éves korában eltűnt fiatal maradványait

Nincs több remény – közel 10 év után azonosították a 22 éves korában eltűnt fiatal maradványait
Egy nagyon régóta tartó ügy zárult le ezzel.

Hamarosan átirányítunk a teljes cikkhez → Liner
Egy nagyon régóta tartó ügy zárult le ezzel.
Hamarosan átirányítunk a teljes cikkhez → Liner